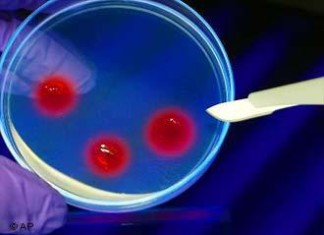
Nueva clase de medicamentos reduce el colesterol en la primera prueba en humanos
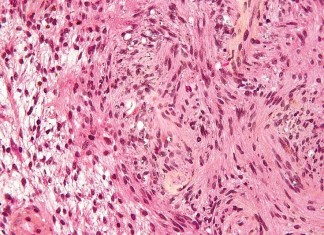
Nuevo fármaco para el cáncer hereditario

Tratamiento del cáncer de mama a través de la inyección en...
El 4 de octubre el Diario de experimentos visualizados, publicará una nueva técnica para el tratamiento del cáncer de mama y la prevención de...
Avispas gigantes matan a 42 personas en China
Varios enjambres de avispas gigantes fueran responsables del asesinato de 42 personas en las últimas semanas, según la agencia estatal de noticias china. Las...
Bacterias que producen gasolina
Gasolina producida por una bacteria? Sí, el equipo de Yong Jun y Choi Sang Sí Lee, Instituto Avanzado de Ciencia y Tecnología de Corea...
Como reducir la Acidez Gastrica
Los participantes de este estudio recibieron un vaso de agua, antiácidos, ranitidina, omeprazol, esomeprazol rabeprazol. Su pH gástrico fue registrado durante 6 horas después...
Nueva clase de medicamentos reduce el colesterol en la primera prueba...
Una sola dosis del pequeño ácido ribonucleico de interferencia (siRNA) fármaco candidato de ALN-PCS para cortar los niveles de colesterol LDL (colesterol malo) en...
Estudio internacional demuestra eficacia de un nuevo medicamento para el cáncer...
Este estudio internacional, publicado en The Lancet, es uno de los más grandes estudios de fase III en el tratamiento de segunda línea del...
Encontrado componente en cítricos que bloquean la formación de quistes renales
Un nuevo estudio publicado en British Journal of Pharmacology ha identificado que un componente de la toronja y otras frutas cítricas, que bloquea con...
Nuevo fármaco para el cáncer hereditario
Científicos del campus del Instituto de Investigación Scripps (TSRI) en Florida han identificado un nuevo fármaco candidato para una forma hereditaria de cáncer que...
Comer berros ayudan a combatir el cáncer de mama
La Universidad de Reading está jugando un papel de liderazgo en un nuevo estudio que analizará los efectos del consumo de berros en pacientes...
Tejido de ovario estimulado in vitro permite a la mujer infertil...
Nueva técnica que utiliza fragmentos de tejido de ovario de e induce el desarrollo de ovocitos en el mismo. Dos mujeres con menopausia prematura...
Fármacos con nuevas sustancias con un triángulo negro invertido
A partir de hoy hay un nuevo símbolo en materia de drogas con sustancias nuevas. El propósito es señalar los medicamentos que requieren especial...
Farmacos y radioterapia pueden llevar a un tratamiento para el tumor...
Los resultados de un ensayo clínico de un nuevo tratamiento para el glioblastoma sugieren que los investigadores podrían haber encontrado un nuevo enfoque para...